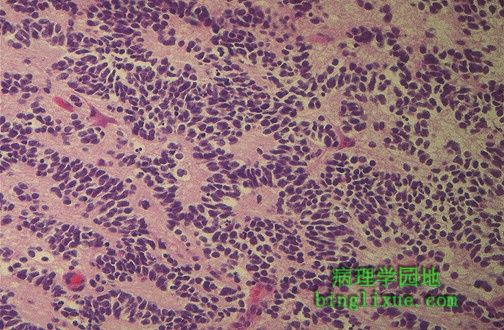

|
发生在脑干之上第四脑室室管膜的室管膜瘤。 组织学上,室管膜瘤是良性肿瘤。 Here is an ependymoma arising from the ependymal lining of the fourth ventricle above the brainstem and bulging toward the cerebellum. Ependymomas are benign histologically. |
 |
矢状面MRI显示分叶状肿块从第四胸椎(L4)水平向下延伸。图为粘液性乳头状室管膜瘤,此处是室管膜瘤的好发部位。 This magnetic resonance imaging (MRI) scan in sagittal view demonstrates a lobulated mass extending down from the level of L4. This is a myxopapillary ependymoma, the most common neoplasm at this site, and a common place for an ependymoma. |
 |
横断面MRI显示分叶状室管膜瘤。 Here is a transverse MRI scan that reveals the lobulated ependymoma. |
 |
CT水平扫描可显示第四脑室的大室管膜瘤。 This horizontal (CT scan) section of the brain reveals a large ependymoma of the fourth ventricle. |
 |
室管膜瘤显微镜图像显示玫瑰花结图案,细胞围绕中央血管区域排列。组织学上是良性肿瘤。 The microscopic appearance of an ependymoma reveals a rosette pattern with the cells arranged about a central vascular space. It is histologically benign. |
 |
黏液性乳头状室管膜瘤,最常出现在脊髓终丝。注意乳突状结构周围的细胞都有粘液样结缔组织核心。如果肿瘤未发生在马尾神经根附近,手术切除将非常容易。 This is a myxopapillary ependymoma, which is typically found arising in the filum terminale of the spinal cord. Note the cells around papillations that have a myxoid connective tissue core. Surgical removal is made easier if this tumor has not grown around nerve roots of the cauda equina. |
 |
不规则颅后窝肿块即髓母细胞瘤,在小脑中线附近并且延伸至脑干之上的第四脑室。它是“小圆蓝细胞”肿瘤,最长发生于儿童。 The irregular posterior fossa mass that is seen here near the midline of the cerebellum and extending into the fourth ventricle above the brainstem is a medulloblastoma. This is one of the "small round blue cell" tumors and it most often occurs in children. |
|
髓母细胞瘤显微镜图像,肿瘤细胞是蓝色、圆型小细胞。 Here is the microscopic appearance of a medulloblastoma with small round blue cells. |
 |
儿童小脑的囊性星形胶质细胞瘤。绝大多数儿童脑肿瘤都发生在小脑幕下,这一点与成人相反。因此,儿童胶质瘤在颅后窝最常见。常是囊性的(所谓的青少年星形细胞瘤)。 Here is a cystic astrocytoma of the cerebellum in a child. Most childhood brain tumors arise below the tentorium, which is the reverse of the adult. Gliomas in children, therefore, are most common in the posterior fossa. They are often cystic (so-called "juvenile astrocytomas"). |
 |
鲜明坚实的肿瘤是从周围神经表面切除下来的,为神经鞘瘤,源于神经鞘施旺细胞。 This discreet firm neoplasm was removed from the surface of a peripheral nerve. It is a schwannoma (neurilemmoma) which arises from the nerve sheath Schwann cells. |